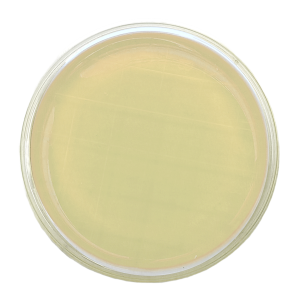
Agar R2A – Irradiado - Placa tipo Rodac Ø 65 mm x 15 mm.

Farmacéutica/Veterinaria
Mostrando 10–14 de 14 resultados
-

AGAR MacCONKEY – Placa tipo Rodac Ø 65 mm x 15 mm.
Inicia sesión para ver el precio -

Agar R2A – Irradiado – Placa de Petri Ø 90 mm x 15 mm.
Inicia sesión para ver el precio -
Agar R2A – Irradiado – Placa tipo Rodac Ø 65 mm x 15 mm.
Inicia sesión para ver el precio -

AGAR SABOURAUD + CLORANFENICOL – Irradiado – Placa de Rodac Ø 65 mm.
Inicia sesión para ver el precio -

AGAR SABOURAUD DEXTROSA – Irradiado – Placa tipo Rodac Ø 65 mm.
Inicia sesión para ver el precio